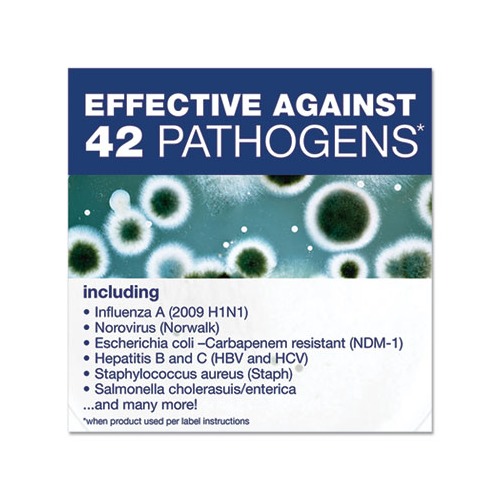
Comet Disinfecting Cleaner w

Comet Disinfecting Cleaner With Bleach is a powerful cleaner that cuts through tough soap scum to leave surfaces clean and sanitized. A unique two-in-one all purpose cleaner formula combines the cleaning power of heavy-duty detergents with the stain-removal power of bleach spray. This Comet cleaner contains no abrasives and uses remarkable cleaning technologies on the full range of tough kitchen and restroom soils. A hospital-use disinfectant when used per label instructions, Comet Disinfecting Cleaner with Bleach kills important pathogens, such as C-diff, hepatitis B, influenza A, and many more. Application: Disinfectant/Cleaner Applicable Material: Ceramics Enamel Fiberglass Glass Grout Laminates Metal Plastic Sealed/Engineered Stone Vinyl Dirt Types: Bacteria Fungus Germs Grease Grime Mildew Mineral Scale Organic Matter Soap Scum Water-Based Soil Scent: Fresh.
| Product Type | Cleaners & Detergents-Disinfectant/Cleaner |
| Application | Disinfectant/Cleaner |
| Applicable Material | Vinyl |
| Dirt Types | Water-Based Soil |
| Scent | Fresh |
| Physical Form | Liquid |
| Packing Type | Spray Bottle |
| Capacity Volume | 32 oz |
| Package Includes | 1 Spray Trigger |
| Compliance Standards | LEED Applicable |
| Pre-consumer Recycled Content Percent | 0% |
| Post-consumer Recycled Content Percent | 0% |
| Total Recycled Content Percent | 0% |
| Disclaimer Statement | Trigger quantities included in each carton may be temporarily reduced due to supply constraints. Triggers are reusable. Each trigger can be used on multiple bottles. |
| Footnote 1 | Trigger quantities included in each carton may be temporarily reduced due to supply constraints. Triggers are reusable. Each trigger can be used on multiple bottles. |
| Package includes | 8 32 oz Bottles 1 Spray Trigger |
| Assembly Code | N |
| Prop 65 Indicator | N |
| Green Indicator | N |
| EPACPGCompliant Code | N |
| Per Package Quantity | 8 Each |

Comment